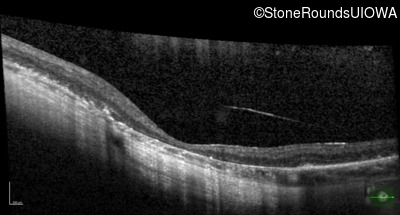
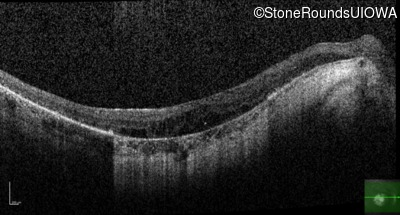
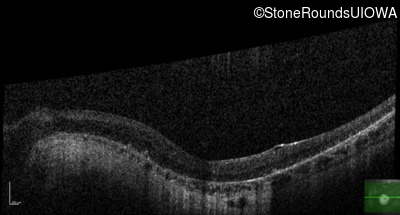
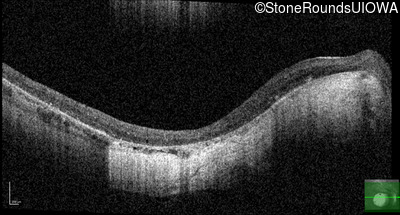
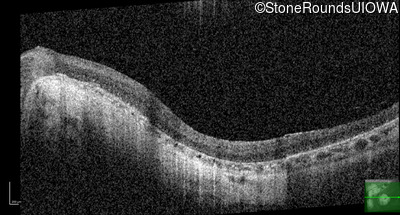
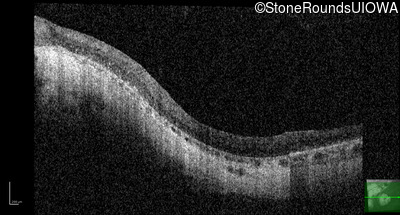
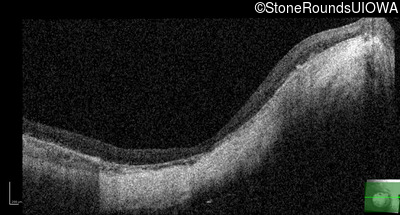

Case
SR599
Student Mode
Bardet Biedl Syndrome (IB2)
Male
Male
Hidden
SR599
Student Mode
Bardet Biedl Syndrome (IB2)
Male
Male
History
This 15 year old male had a macular abnormality noted two weeks ago when he was refracted for his first pair of glasses. Bone spicule-like pigmentation was first noticed a year later (age 16) during a routine follow-up eye exam.
| Age at visit: 47 years |
| Age at visit: 52 years |
| Age at visit: 55 years |
| Age at visit: 57 years |
Diagnosis & molecular findings
| Disease | Gene | Allele 1 variant(s) | Allele 2 variant(s) | Inheritance mode |
|---|---|---|---|---|
| Bardet Biedl Syndrome | BBS1 | Met390Arg ATG>AGG | Met390Arg ATG>AGG | AR |
Disease:
Gene:
Allele 1:
Met390Arg ATG>AGG
Allele 2:
Met390Arg ATG>AGG
Inheritance:
AR